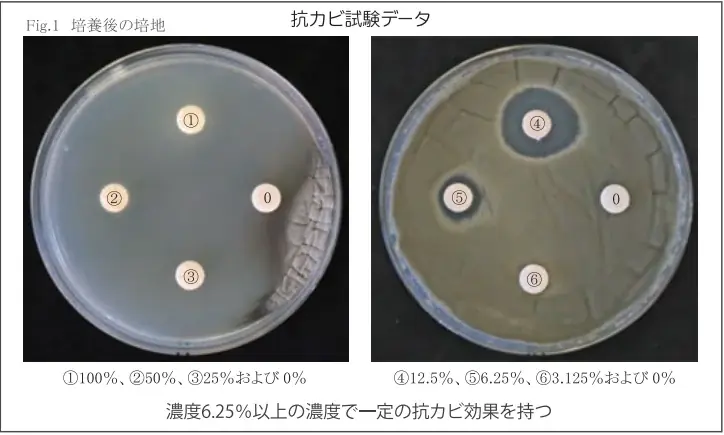
商業施設トイレ芳香剤 1か月無償デモ　新商品「パピルス」発売記念エフグラスキャンペーンを開催 画像 5

新商品パピルス発売記念 エフグラス1か月無料デモ
ベストカレンダー編集部
2026年1月14日 16:11
エフグラス1か月無料デモ
開催期間:1月1日〜4月30日
📅 カレンダーに追加:Google|iPhone/Outlook

トイレ空間ごとに選べる「1か月無料デモ」キャンペーンの全体像
株式会社アメニティ(本社:横浜市、代表取締役:山戸伸孝)は、2026年1月14日付の発表にて、新商品である紙製消臭剤容器「パピルス」の発売を記念し、フレグランス消臭剤「エフグラス」シリーズの体験キャンペーンを全国で実施すると発表しました。キャンペーン期間は2026年1月1日から同年4月30日までで、アメニティのネットワークを通じて展開されます。
本キャンペーンは、トイレの広さや用途に応じて選べる2つのプランを用意した「1か月無料デモプラン」です。機器レンタル代・消臭剤代が含まれ、実際の設置環境で1か月間、消臭と香りの効果を確認できます。対象は商業施設やオフィスビル、飲食店など様々な空間を想定しています。

プランA:小規模スペース・個室向け(パピルス)
プランAは狭い個室や小規模スペース向けの構成です。新商品「パピルス」は、紙製の消臭剤容器で、ファンを使わない自然拡散方式を採用している点が特徴です。電池や電源を必要としないため、配線が難しい場所や運用上電源を確保しにくい個室トイレでの導入に適しています。
パピルスは紙製のため軽量で交換が容易に行えます。狭い個室でも消臭成分が十分に行き渡るよう設計されており、日常的な臭気対策や芳香演出を静かに行うことができます。導入時には配置場所や個室の換気状態に応じた最適な設置方法を提案します。

プランB:広いスペース・強力消臭向け(ボンボア)
プランBは商業施設の共用トイレやバックヤード、広いロビーなど大きな空間向けの構成です。こちらで使用する送風機「ボンボア」はシロッコファンを用いて消臭剤を拡散する機器で、ファンの力で芳香・消臭成分を広範囲に送ることが可能です。
広いスペースでは自然拡散だけでは効果が薄れる場合があるため、ボンボアのような送風機を併用することで消臭成分を効率よく拡散し、均一な香りの演出とニオイ対策が期待できます。商業施設や飲食店の共用部など、広域の臭気管理に向いています。

エフグラスの香りラインナップと科学的検証データ
フレグランス消臭剤「エフグラス」シリーズは、植物精油を基にしたアロマ系消臭剤です。香りは用途や空間イメージに合わせて選べるラインナップが用意されており、消臭と香りの両面からトイレ空間を整えます。
第三者機関による試験での数値的な裏付けも公表されています。ユーカリを使用した場合のアンモニア濃度低減効果や、特定濃度での抗カビ効果が確認されており、消臭性能に関する客観的なデータが存在します。

香りのラインナップと特徴
エフグラスシリーズは下記の香りを取り揃えています。用途や期待される効果に合わせて選択できるようになっています。
- ユーカリ(おすすめ):消臭効果が高く、強いニオイ対策に適している香り。
- ウッディ:森林浴を想起させる落ち着いた空間を演出する香り。
- メントール:清涼感のあるストロングミント。爽快感を重視する空間向け。
- リラックス:ラベンダー基調の穏やかな香り。落ち着きを与える用途に。
- ビタミン:柑橘系をイメージしたフレッシュな香り。清潔感を演出する場面に向く。
これらの香りは、トイレ特有の臭気成分の抑制と、利用者に与える印象の改善を目的に選定されています。用途に応じて香りを変えることで、施設全体のイメージ統一も図れます。
第三者機関試験の結果(数値データ)
アメニティが公表した試験結果によれば、エフグラス(ユーカリ使用)ではアンモニア濃度が60分後に98%減少するという結果が確認されています。この数値は短時間でのアンモニア低減効果を示しており、トイレの嫌気性臭気に対する効果を評価する上で有用です。
また、抗カビ効果確認試験では、一定の濃度条件において抗カビ効果が認められ、6.25%以上の濃度で抗カビ効果が確認された 本キャンペーンは、全国のアメニティネットワークを通じて提供されます。期間は2026年1月1日〜2026年4月30日までで、期間内に申し込みいただいた施設を対象に、機器レンタル代と消臭剤代を含む形で1か月間の無償デモが行われます。 申し込みの際は、施設のトイレの用途(男女共用、個室数、換気状況など)と設置スペースの広さを伝えることで、プランA(パピルス)またはプランB(ボンボア)いずれかの提案を受けることができます。実際の設置にあたっては、アメニティ側が設置方法や運用の注意点を案内します。 問い合わせは下記の連絡先にて受け付けています。掲載されている連絡先は、株式会社アメニティが公表したものです。事業内容としてはトイレメンテナンス、消臭剤開発、設備機器レンタル、フランチャイズ事業などを手掛けています。 また、キャンペーンの対象分野としては「商業施設・オフィスビル」「レストラン・ファストフード・居酒屋」などが想定されています。関連するキーワードは「トイレ」「キャンペーン」「期間限定」「消臭」「商業施設」「新商品」「無料」です。 以下の表にて、本記事で取り上げたキャンペーンの主要項目を整理します。キャンペーンの期間、対象プラン、提供製品、香りのラインナップ、試験結果、問い合わせ先など、重要事項を一目で確認できるようにまとめました。 以上のとおり、アメニティの今回のキャンペーンは、紙製容器「パピルス」や送風機「ボンボア」と、植物精油を用いた「エフグラス」シリーズを組み合わせ、実使用環境での効果を確かめられる形で提供されます。期間は2026年1月1日から4月30日までで、申し込みや詳細な運用方法は上記の問い合わせ先で案内されています。
試験項目 条件・対象 結果 備考 アンモニア消臭性試験 エフグラス(ユーカリ)、60分測定 アンモニア濃度98%減少(60分後) 第三者機関による測定 抗カビ試験 エフグラス(一定濃度)、菌種別試験 6.25%以上の濃度で抗カビ効果確認 第三者機関による確認試験 申込み方法、キャンペーン対象範囲、会社情報と問い合わせ先
問い合わせ先と会社情報
本記事の要点整理
項目 内容 キャンペーン名 新商品「パピルス」発売記念 エフグラスキャンペーン(1か月無料デモ) 期間 2026年1月1日〜2026年4月30日 提供内容 機器レンタル代・消臭剤代を含む1か月間の無償デモ プランA パピルス(紙製消臭剤容器、自然拡散、電源不要)—小規模・個室向け プランB ボンボア(シロッコファン送風機)—広いスペース・強力消臭向け フレグランス(エフグラス) ユーカリ、ウッディ、メントール、リラックス、ビタミン 科学的データ アンモニア濃度が60分後に98%減少(ユーカリ使用)、抗カビ効果は6.25%以上で確認 対象カテゴリ 商業施設・オフィスビル、レストラン・ファストフード・居酒屋 等 問い合わせ 株式会社アメニティ / 〒221-0863 横浜市神奈川区羽沢町685 / TEL:045-371-7676 / amenity@do-amenity.co.jp / https://do-amenity.co.jp/